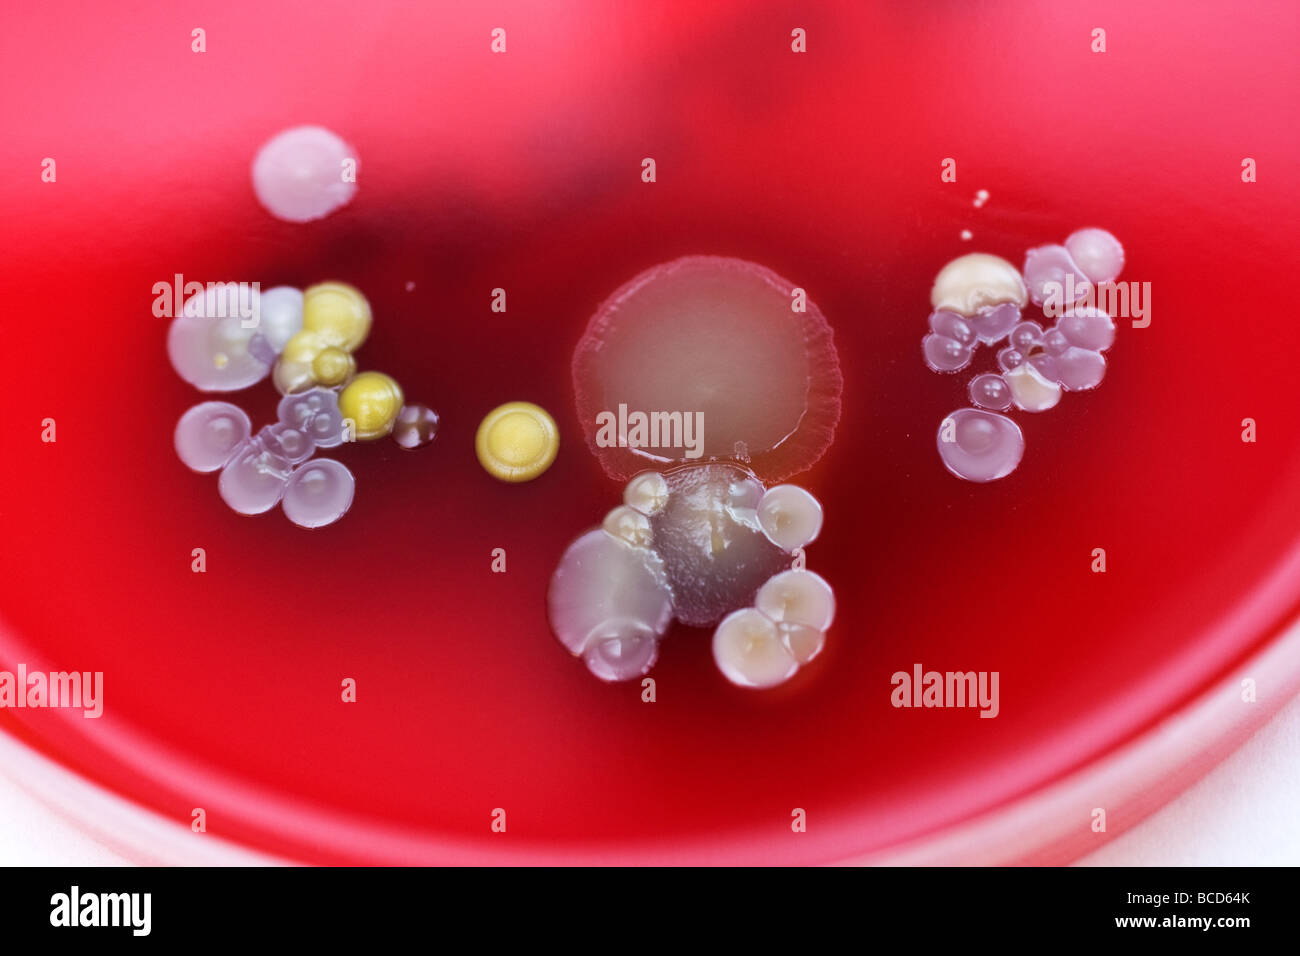
Les boîtes de Petri contenant des colonies de Staphylococcus epidermidis & Diptheroids Banque D'Images

Les boîtes de Petri contenant des colonies de Staphylococcus epidermidis & Diptheroids
RMID:ID de l’image:BCD64K
Détails de l'image
Contributeur:
Trevor SmithID de l’image:
BCD64KTaille du fichier:
50 MB (1,6 MB Téléchargement compressé)Autorisations:
Modèle - non | Propriété - nonUne autorisation est-elle nécessaire?Dimensions:
5120 x 3413 px | 43,3 x 28,9 cm | 17,1 x 11,4 inches | 300dpiDate de la prise de vue:
2009Informations supplémentaires: